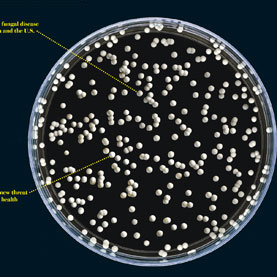
תמונת תרבית פטריות.קרדיט: זַכַּארי זַוִויסְלַאק | Scientific American

בקיצור
- ב-2001, באי ונקובר, בקולומביה הבריטית שבקנדה, התגלה שפטריית שמרים נישאת באוויר גורמת לאנשים בריאים לכאורה למחלה קשה. זה המקרה הידוע הראשון של פטרייה המחוללת מחלות בבני אדם, שנעשתה לפתע אלימה באזורים שבהם לא הייתה מוכרת כלל קודם לכן.
- איתור מקום מוצאה של הפטרייה התברר כמשימה קשה. בסופו של דבר, החוקרים נוכחו שהיא מסתתרת במקומות מפתיעים, וייתכן שהיא נעשתה אלימה עקב שינוי האקלים ועבודות לפיתוח הקרקע בקולומביה הבריטית.
- ההתפרצות צפויה להימשך. כלי אבחון משופרים יכולים לעזור לנו להתכונן. פיקוח הדוק יותר על מעבר צמחים ובעלי חיים בין ארצות ופיתוח תרופות וחיסונים טובים יותר נגד פטריות יכולים לעזור גם הם.
בשנת 2001 נסחפו דולפינים מתים שריאותיהם היו גדושות בכמויות גדולות של שמרים לחופים הדרומיים-מזרחיים של האי ונקובר בקולומביה הבריטית שבקנדה. האברים הנפוחים היו כבדים פי כמה ממשקלם התקין וכמעט לא היה בהם מקום לאוויר. הווטרינרים העובדים באי מעולם לא ראו דבר מעין זה. גם החתולים והכלבים של האזור התקשו לנשום. אצל החתולים המחלה גרמה לתסמין מבעית במיוחד: פצעים זבים בראשיהם שנוצרו לאחר שהזיהום הפטרייתי כרסם בדופנות הגולגולת ופער בה נקבים. בה בעת חלו כמה אנשים באי, המצוי ממערב לחופי קנדה, במחלה לא מוכרת של דרכי הנשימה. הם השתעלו ללא הפוגה, כוחם הלך והידלדל ושנתם הופרעה. צילומי רנטגן של החזה גילו מוקדים מפחידים בריאות או במוח. אולם ביופסיה של הרקמות העלתה שלא מדובר בסרטן, אלא בשמרים, פטריות חד-תאיות שאינן יוצרות קורים או מבנים רב-תאיים.
למרות ההבדלים בתסמינים, הגורם לסבלם של חיות המחמד, הדולפינים ובני האדם היה אחד: קריפטוקוקוס גאטי (Cryptococcus gattii), פטרייה שמעולם לא נצפתה באי בעבר, והסברה הייתה שהיא שורדת רק באקלימים טרופיים וסובטרופיים. הפטרייה נמצאה בסביבת האי ונקובר, אך איש לא ידע מאין הגיעה וכמה זמן כבר הייתה שם. ומה שמדאיג ביותר, איש לא ידע כמה יחלו במחלה וכמה רחוק יגיע הפולש הזה.
והיו סיבות טובות לדאגה.
פטריות הן מכה עתיקת יומין הפוקדת צמחים זה זמן רב. במזרח ארה"ב ובמקומות אחרים הן התפרסמו ביכולתן להפיל עצי בוקיצה וערמונים נישאים. אבל לאחרונה החלו להתגלות מגפות של זיהום פטרייתי בשכיחות מבהילה בקרב בעלי חיים. דיווחים על אודות פטריות מחוללות מחלה המתפשטות כאחוזות דיבוק הגיעו מבריכות יער בדרום אמריקה, שם עורן של צפרדעים שכוסה בפטריות עוצר את פעולת לבן, ועד מערות במזרח ארה"ב, שם עטלפים רועדים מכוסי עובש נופלים מתקרות המערות. פטריות שמדביקות בני אדם נודעו בעבר בעיקר כמקור השראה לפרסומות גרועות ומעוררות גיחוך העוסקות בזיהומי עור מעצבנים וחסרי חשיבות, ולא כמשהו שגורם למחלות קשות מאוד. מערכת החיסון האימתנית שלנו וטמפרטורת הגוף החמה, הגבוהה הרבה יותר מכושר סבילותן של רוב הפטריות, הבטיחו שרוב האנשים שבריאותם הכללית תקינה יהדפו בקלות התקפות פטרייתיות חמורות.
היו יוצאי דופן מעטים: בארה"ב מחלות המועברות בשאיפת אוויר, כגון קוֹקסידיודומיקוזיס בדרום-מערב המדינה והיסְטוֹפְּלַסְמוֹזיס, הנפוצה במערב התיכון ובדרום-מערב, אורבות מאז ומתמיד בשקט לאנשים בריאים. מסיבות שאינן מובנות במלואן, קוקסידיודומיקוזיס התפרצה בהיקף גדול פי שמונה מן הרגיל בשנים 1999 ו-2011. כצפוי, בעשורים האחרונים גאו זיהומים פטרייתיים בקרב מיליוני אנשים שמערכות החיסון שלהם נפגעו מ-HIV או מפעולתן של תרופות המדכאות את מערכת החיסון, הניתנות לאחר השתלות או כטיפול במחלות מסוימות. כשמערכות ההגנה של הגוף מנוטרלות, מזהמים גורמי מחלות משגשגים באין מפריע. ועם זאת, מתקפות של פטריות הפוגעות בעת ובעונה אחת באנשים בריאים רבים היו נדירות ונגרמו בעיקר מפטריות בתחום בתי הגידול הרגילים שלהן שנתקלו באקראי בתנאי סביבה נוחים להתרבות.
הפטרייה ק' גאטי היא סיפור שונה. עד הופעתה על האי ונקובר היא אמנם הדביקה מפעם לפעם אנשים בריאים יחידים במקומות אחרים, אבל מעולם לפני כן לא חוללה התפרצות, או גל של זיהומים לא צפויים. הופעתה בקנדה מסמנת ככל הנראה קפיצה לטריטוריה חדשה בעלת אקלים קריר הרבה יותר, שבה נעשו היצורים החד-תאיים האלה לאלימים הרבה יותר באופן בלתי מוסבר. מתחילת ההתפרצות ועד סוף 2012 נמסר על 337 תושבי קולומביה הבריטית שנפגעו מן הזיהום, שני שלישים מהם תושבי האי ונקובר, אומרת אֶלֶני גַלַניס, אפידמיולוגית במרכז לבקרת מחלות של קולומביה הבריטית. ב-2005 החלה ק' גאטי להדביק אנשים גם במקומות דרומיים יותר, בצפון-מערב ארה"ב, לחופי האוקיינוס השקט. מאז ועד עתה נדבקו לפחות 100 אנשים באזור, ו25% עד 30% מהם מתו. "זהו שיעור תמותה גבוה למדי לגבי פטרייה שההידבקות בה היא סביבתית," אומר ג'וזף הייטמן, ראש המרכז למחלות זיהומיות באוניברסיטת דיוק. אף שלא מדובר בחולי איידס, אצל כמחצית מהם מערכת החיסון הייתה מוחלשת עקב מתן תרופות או בהשפעת המחלה עצמה, ולרבים מן האחרים היו בעיות רפואיות משותפות, כגון סוכרת ומחלות של הריאות, הכליות או הלב, שיכולות להחליש את מערכת החיסון אך במידה פחותה יותר. אבל כ-20% או יותר היו בריאים טרם ההידבקות. "רבים מן החולים האלה היו בריאים לגמרי, הרבו לשהות בחוץ, ופתאום הם נעשו חולים מאוד," מוסיף הייטמן.
היום יש סימנים מובהקים לכך שהתפרצות המחלה שגורמת הפטרייה תמשיך להתפשט דרומה. האימונולוג ארטורו קַסַדֶוַואל מן הקולג' לרפואה על שם אלברט איינשטיין חושב שהשֶמֶר הזה יגיע בסופו של דבר לפלורידה. המאורעות בקולומביה הבריטית ובצפון-מערב ארה"ב מציבים ציון דרך בהיסטוריה של מחלות האדם: זו ההתפרצות הידועה הראשונה של מחלה שהגורם לה הוא פטרייה שפתאום התפתחה אצלה אלימות מוגברת. ועוד ציון דרך היסטורי: הדבר קרה במקום שבו האורגניזם לא היה מוכר כלל קודם לכן. הסיפור של ק' גאטי מציב אפוא תחזית מטרידה: אנשים בריאים אינם יכולים עוד להניח שהם מחוסנים מפני התפרצויות מסוכנות של פטריות שנעשו אלימות לפתע. למעשה, ככל שגוברת התחממות כדור הארץ, אפשר שאנחנו מזמינים התקפות נוספות כאלה.
בכל מקום ובלי אפשרות לעצרן
התובנות האלה היו עדיין הרחק בעתיד, ביוני 2001 באי ונקובר, כשהממונים על בריאות הציבור עמדו בפני מתקפת הפתע. בעבור חוקר המחלות מאריי פייף, שעבד אז במרכז לבקרת מחלות של קולומביה הבריטית, הסימן הראשון לכך שמשהו לא בסדר היה שיחת טלפון מן הווטרינר של המחוז, שבה דיווח על עלייה חריגה בהידבקות בקריפטוקוקוס בקרב כלבים וחתולים באי. רופאים מקומיים אישרו את קיומה של עלייה דומה אצל בני אדם, ובדיקות הראו שהאשם לא היה המין הרגיל, קריפטוקוקוס נאופורמנס (Cryptococcus neoformans), אלא מין ביולוגי אחר, ק' גאטי. הצוות הסתער על אוסף התרביות של המרכז כדי לבדוק את האפשרות שק' גאטי הדביקה אנשים באי ונקובר מאז ומתמיד ורק זוהתה בטעות כק' נאופורמנס. התברר שהדבר נכון לגבי כמה הדבקות החל מ-1999 אבל לא בשנים שלפני כן. פייף, האחראי כעת לבריאות ולרפואה ציבורית ברשות הבריאות של האי ונקובר, נקט כמה גישות כדי לאתר היכן בדיוק מסתתרת הפטרייה. כיוון אחד היה הקמת צוות חוקרים שיחפשו חולים חדשים באי ובכל רחבי קולומביה הבריטית. הצוות ראיין מטופלים ובעלים של חיות מחמד נגועות, אסף את פרטי התסמינים, חיפש מאפיינים משותפים וגורמי סיכון, כגון מחלות קודמות ונסיעות למקומות מרוחקים, ואפילו בירר אם בחצרותיהם של הקרבנות גדלים עצי אקליפטוס. הפטרייה התגלתה על עצים אלה באוסטרליה, שבה אנשים נדבקו מדי פעם בפעם בפטרייה במשך שנים. הם ציינו את מיקומם של החולים במפות והשוו בין החולים ובין אנשים שלא חלו, על פי שיטה הקרויה חקר מקרי ביקורת, כדי לזהות הבדלים או מגמות.
כדי לאתר את עקבותיה של ק' גאטי בטבע פנה פייף אל קארן ברטלט מאוניברסיטת קולומביה הבריטית, מומחית להתנהגות של חלקיקים ביולוגיים נישאים באוויר, כגון נבגים של פטריות, או חלקיקים אחרים המגיעים לדרכי הנשימה של אורגניזמים. מאחר שהפטרייה נמצאה על עצי אקליפטוס באוסטרליה, היא התחילה את עבודתה בלקיחת דגימות מעצים שצמחו על האי ונקובר. אבל המשטחים שהכינה ברטלט מעצים אלה ואחרים ומן הקרקע לא העלו דבר.
גם חקר מקרי הביקורת לא הניב תוצאות. לא נמצא שום גורם סביבתי, כגון עבודה בגינון, גיזום עצים או הנחת משטחים של עיסת קליפות עץ, שנראה כי הוא מגביר את הסיכון של תושבי האי. החולים היו פזורים באקראי מצפון לדרום לאורך החוף המזרחי של האי בלא מוקד מובחן אחד. יתר על כן, לא כל החולים נסעו בתקופה שקדמה למחלה לאוסטרליה או למקום אקזוטי שממנו יכלו להביא את הפטרייה.
החוקרים עמדו בפני מבוי סתום. התסכול שלהם נמשך שישה חודשים. פריצת הדרך הגיעה כשנמצאו כמה חולים שלא גרו באי ונקובר אלא נסעו לבקר בו. מעטים מהם ביקרו בפארק של חוף ראתְ'טרֶווֹר. צוות של לוקחי דגימות נשלח לפארק בתחילת 2002. בסופו של דבר, באחת הדגימות, שנלקחה מאשוח דאגלס, מין ביולוגי נפוץ באותה הסביבה, נמצאה נוכחות של ק' גאטי. איש לא ציפה שהפטרייה האקזוטית לכאורה תסתתר בעצים ילידים. הצוות של ברטלט בודד 57 דגימות של הפטרייה מ-24 עצים בפארק המשתייכים לכמה מינים ביולוגיים ילידים. עד סוף הקיץ ההוא גילתה ברטלט את הפטרייה בקרקע, באוויר ועל עצים בעיר ויקטוריה, הניצבת בקצה הדרומי של האי, ובמעלה החוף המזרחי עד נהר קמבל, ומערבה משם, במרכז האי. בשטח זה חיה רוב אוכלוסיית האי ונקובר, ולכן סברו החוקרים כי קרוב לוודאי שכל התושבים ייחשפו, או כבר נחשפו, ואין מה לעשות בעניין זה.
חדשות מדאיגות יותר הגיעו בהמשך. נתונים שנאספו בין 2002 ל-2006 הראו כעבור זמן ששיעור ההידבקות באוכלוסיית האי ונקובר היה 27.9 הידבקויות למיליון: שיעור גבוה פי שלושה משיעור ההידבקות של בני אדם בצפון הטרופי של אוסטרליה. אפשר בהחלט שהצפון אמריקנים פוגשים בזן אלים הרבה יותר, אם כי גם היעדר חשיפה קודמת עשוי להסביר את דפוס ההידבקות; אם הפטרייה היא אורחת חדשה, רק מעטים מן האוכלוסייה, אם בכלל, כבר נתקלו בה ויכלו לפתח חסינות נגדה בשלב מוקדם יותר בחייהם. בדיקות שנעשו לאורגניזם העלו ממצאים מטרידים. הוא עמיד בפני מים מתוקים. הוא יכול לשרוד במים מלוחים. הוא שורד באוויר. הוא יכול לשרוד שנים בבוץ שעל סוליות נעליים. עבודת מחקר מקבילה הראתה שק' גאטי נמצאת בתנועה. ב-2004 החלו לחלות במחלה אנשים מן היבשת של קולומביה הבריטית שמעולם לא היו באי ונקובר. מודלים סטטיסטיים הראו שהאורגניזם מעדיף חורפים חמימים יחסית, גבהים נמוכים ותנאי יובש. אזורים בדרום נראו כקרקע פורייה בשבילו. בפברואר 2006 הגיע קשיש חולה לויקמיה לרופא שלו והתלונן על שיעול. הקשיש, שחי באיי סן חואן ממערב לחופי מדינת וושינגטון, טופל טרם פנייתו בסטרואידים המדכאים את מערכת החיסון. צילום רנטגן של החזה שלו גילה מוקד של ק' גאטי. אנליזה גנטית שעשה הייטמן בשיתוף עם קִירֶן מאר, רופא-חוקר שעבד אז במרכז פרד האצ'ינסון לחקר סרטן בסיאטל, העלתה שהפטרייה זהה לזן שנמצא באי ונקובר. אף על פי שהאיש חי קילומטרים מעטים מן הגבול הימי עם קנדה, הוא לא נסע לקנדה מעודו. הפטרייה באה אליו.
למה עכשיו?
אף שכבר באמצע העשור הקודם נוכחו החוקרים שאין כמעט מה לעשות כדי לעצור את התפשטותה של הפטרייה בצפון אמריקה, עדיין העסיקה אותם השאלה כמה זמן הפטרייה קיימת בקולומביה הבריטית ובצפון-מערב אמריקה, מאין הגיעה ומה גרם לה להדביק לפתע אנשים רבים כל כך. הם מצאו רמזים לתשובות בעזרת ניתוח רצף הדנ"א שלה.
המחקר הגנטי גילה כי ייתכן שהפטרייה נמצאה בסביבת האי ונקובר כבר כמה עשרות שנה לפני 1999, אומר הייטמן. ניתוח הדנ"א של הזן העיקרי של ק' גאטי המצוי באי, המסומן VGIIa, ונמצא אחראי ל-90% מן ההדבקות באי ונקובר, מצא רצף גנטי מסוים הזהה ל-30 מקטעים מקבילים ויותר של דנ"א שנמצאו בדגימת ליחה שנלקחה מאדם בסיאטל ב-1971. היסטוריית הנסיעות שלו אינה ידועה, וייתכן שביקר באי ונקובר. בלי קשר לכך, הראיה הזאת מלמדת כנראה שהזן VGIIa נמצא בחופים הצפוניים-מערביים של אמריקה לפחות 40 שנה. בשנים שחלפו מאז ההתפרצות מצאו המדענים בצפון אמריקה זנים אלימים פחות של הפטרייה שאינם גורמים להתפרצויות, ולכן ייתכן שהקטע VGIIa הוא תוצר אבולוציה שהתרחשה שם. אבל ק' גאטי יכלה להגיע גם מאפריקה, מאוסטרליה או מאמריקה הדרומית, שגם בה המין הוא אנדמי.
זן שני של הפטרייה, המסומן VGIIb, אינו ניתן להבחנה מזן הנפוץ עתה באוסטרליה. החוקרים הבינו מאוחר יותר שהוא גרם למחלות באי ונקובר ב-1999 יחד עם VGIIa ושהוא אחראי ל-10% מן ההדבקות בהתפרצות הראשונה. ייתכן שאוסטרליה היא המקור לזן זה. באורגון נמצאים עתה שני הזנים, ונוסף עליהם שלישי: VGIIc. זה האחרון התפשט באורגון במפתיע ב-2005, אך לא ידוע אם מוצאו שם או במקום אחר.
מדאיגה גם העובדה ששני הזנים VGIIa ו-VGIIc שנמצאו בדגימות בעכברים במעבדתו של הייטמן, הם הצורות האלימות ביותר של קריפטוקוקוס שחקרה המעבדה אי פעם. הממצא הזה ואחרים מעידים, לדעת הייטמן, שייתכן שרבייה זוויגית מסוג כלשהו בין זנים לא מוגדרים של הפטרייה היא שהניבה את שני הזנים והעניקה להם את האלימות המוגברת שלהם. רבייה זוויגית מעודדת היווצרות גיוון בקרב הצאצאים באמצעות ערבוב הדנ"א של ההורים ויצירת צירופים חדשים. בפטריות מחוללת פעולת הזיווג כשלעצמה מוטציות שיכולות להניב תכונות חדשות. ההתפרצויות המשוערות של סקס פטרייתי יכלו להתרחש באותה מידה בצפון אמריקה או במקומות משכנה הנפוצים של הפטרייה באוסטרליה, באמריקה הדרומית או באפריקה, שם החוקרים עדיין לא מצאו את פטריית דור ההורים.
לא ידוע גם אם הזנים שהתפרצו הגיעו מחוץ ליבשת, ואם כן, אם עשו את דרכם לצפון אמריקה בנפרד או ביחד. המדענים יכולים לחשוב על תרחישים רבים להגעתם: ייבוא של צמחים, קרקע או בעלי חיים או נדידות למרחקים ארוכים באמצעות רוחות או זרמי האוקיינוס – כל אלה הוצעו. הפטרייה יכלה לתפוס טרמפ על מי נטל (זיבורית) של ספינה. דולפינים נגועים יכלו לחצות את האוקיינוס השקט בכוחות עצמם, ולשחרר את האורגניזם לקרקע, או להעביר אותו לאוכלי פגרים לאחר היסחפות גופותיהם לחוף. בוץ על גלגלי מכוניות או נעליים יכול לשאת את הפטריות ממקום אחד לאחר. המסע או המסעות שהביאו את הפטריות לצפון אמריקה יכלו להתרחש לפני 10,000 שנה, או לפני 43 שנים.
עם זאת, יש לפחות רמז אחד לפתרון השאלה כמה זמן נמצאות הפטריות בצפון-מערב אמריקה. הגיוון הגנטי של פטריות המצויות זמן רב במקום אחד נוטה לגדול. שלושת הזנים של הפטרייה הגורמים להתפרצויות באזור הם שבטיים, כלומר, כל הפרטים מזן יחיד, b, a או c, דומים מאוד זה לזה. "אילו היו כאן 100,000 שנים, היינו מצפים למצוא גיוון הרבה יותר גדול באוכלוסייה, ואיננו רואים גיוון כזה," אומר הייטמן. "מנקודת המבט שלי, זה עשוי להיות הטיעון החזק ביותר בזכות הסברה שאולי [הפטריות האלה] באמת הגיעו לכאן לפני 50 או 70 שנים או 100 שנים" ולא אלפי שנים קודם לכן.
אשר לשאלה למה הפטרייה לא גרמה להתפרצויות עד הזמן האחרון אף שהייתה בסביבה לפחות 40 שנה, תשובה אפשרית אחת היא שינוי האקלים. הטמפרטורה הממוצעת באי ונקובר עלתה במעלה אחת או בשתי מעלות צלזיוס ב-40 השנים האחרונות, אומרת ברטלט. "זה לא נשמע הרבה כל כך, אבל זה יכול להיות הבדל עצום בשביל יצורים חד-תאיים," היא מוסיפה. בכל אחת מן השנים 1991, 1993, 1996 ו-1998 טמפרטורות הקיץ היו גבוהות מן הממוצע באי ונקובר. ייתכן שטמפרטורות גבוהות יותר אפשרו לאורגניזם הסובטרופי, שקודם לכן רק התקיים על סף ההישרדות, להתחיל לשגשג. ככל שכדור הארץ מתחמם, אומר קסדוואל, פטריות מחוללות מחלות החובבות חום יכולות להרחיב את התפוצה שלהן, ולחדור לבתי גידול שקודם לכן לא היו ידידותיים כלפיהן. ואמנם כבר ידוע שמאז 1960 נעות פטריות המחוללות מחלות בצמחים לעבר הקטבים בקצב נמרץ במיוחד של כ-7.5 קילומטר לשנה בממוצע בתגובה על שינוי האקלים. בינתיים אקלימים חמים יותר עשויים לעודד בפטריות אחרות התפתחות של סבילות לטמפרטורות חמימות יותר. הגנום הפטרייתי המורכב, הגדול מזה של חיידקים ושל נגיפים, מקנה לבעליו מגוון של אפשרויות תגובה על עקה, המאפשרות הסתגלות לחום. אפילו עליות קלות בסבילות לחום עשויות לאפשר לפטריות שהיו על סף היכולת לחולל מחלה לסבול את טמפרטורת הגוף הגבוהה שלנו ולהתרבות בו, במקום למות לאחר שפלשו לתוכו. אם תרחישים כאלה אכן מתרחשים, יש כאן חדשות רעות לבני האדם, המסתמכים על טמפרטורת גוף גבוהה כעמוד תווך של ההגנה מפני פטריות.
נוסף על התחממות האקלים, בשנות ה-90 המאוחרות היינו עדים לפיתוח מואץ של הצד המזרחי של האי ונקובר. יערות נכרתו, נסלל כביש מהיר ארוך, והאדמה נחפרה ונהפכה לצורכי בנייה. הפיכת הקרקע וכריתת עצים יכלו לשחרר את האורגניזם ולהפיץ אותו מן הנישה הקטנה שלו לעולם הרחב, מציינת ברטלט. ההופעה של ק' גאטי כמחולל מחלה באזור זה יכלה להיות תוצאת צירוף אקראי של גורמים שפעלו בו בזמן: כמה שנים של חורפים חמימים יחסית וקיצים יבשים; הפיכת הקרקע; והיותו של האזור פופולרי הן בקרב תיירים והן בקרב אנשים שיצאו לגמלאות, הנוטים להיות רגישים להידבקות יותר מצעירים.
איומים צפויים
במידה רבה אין לנו להאשים אלא את עצמנו בהתפתחות הערב רב הזה של פטריות מחוללות מחלות המאיימות על צמחים, על בעלי חיים ועל בני אדם – ולא רק מפני שיש לנו חלק נכבד בשינוי האקלים. בני האדם סייעו להם בנחישות להימלט ממשכנם הקודם המוגבל באמצעות הסחר הבין-לאומי. סביר מאוד שסחר בין-לאומי הפיץ את כימשון תפוחי האדמה מאירלנד לאירופה, את כימשון הערמונים לצפון אמריקה ואת פטריית זיהומי העור chytridiomycosis לדו-חיים בכל העולם. ההתמכרות שלנו להובלות על פני הגלובוס יצרה למעשה שירות שידוכים לפטריות. הפטריות כקבוצה הן יצורים מיניים נלהבים. כשבני אדם מפגישים פטריות שחיו בנפרד בשל חסמים גאוגרפיים, אבל הן עדיין מסוגלות להזדווג, הזיווגים המתקבלים יכולים להעמיד זנים חדשים ואלימים יותר המסוגלים להדביק אורגניזמים שאבותיהם לא יכלו לפגוע בהם, או לשגשג בסביבות חדשות. המשך הסחר או הרחבתו יגדילו את הסיכויים של החדרת מחוללי מחלה קיימים לפונדקאים חסרי מגן ושל הופעת מחוללי מחלה חדשים עקב הזדווגויות של פטריות.
במידה רבה אין לנו להאשים אלא את עצמנו בהתפתחות הפטריות האלה המחוללות מחלות בצמחים, בבעלי חיים ובבני אדם.
אף שאין כמעט מה לעשות כדי לעצור את ההתפשטות של ק' גאטי, אנחנו יכולים לנקוט צעדים כדי להקטין את הסיכויים שפטריות ידהרו ויזרעו חורבן באוכלוסיות תמימות, וכדי להיות מוכנים כשתתרחש התפרצות. רצוי להתחיל בשיפור האבחון של מחלות פטרייתיות והמעקב אחריהן. מאחר שמחלות פטרייתיות אינן שכיחות בקרב אנשים בריאים, הרופאים בדרך כלל מבקשים בדיקות לזיהוי שלהן, והדבר מביא לידי איחור באבחון והתפתחות תסמינים קשים יותר לטיפול לאחר האבחון. לפי שעה שיטות האבחון של פטריות רבות אינן ספציפיות או רגישות די הצורך ועלולות להיות יקרות מדי במדינות עניות. ארגון הבריאות העולמי לא הכין תכנית למניעת הידבקות בפטריות, ורק מעט גופי בריאות הציבור, מלבד המרכזים האמריקניים לבקרת מחלות ולמניעתן, מנהלים מעקב מסודר אחר הידבקות בפטריות.
קו הגנה נוסף עשוי להיות הגברת הבטיחות של העברת צמחים ובעלי חיים. מאחר שמחוללי מחלות רבים של בני אדם חיים גם הם בקרקע ועל צמחים, פיקוח מוגבר על ייבוא חומרים כאלה, בדיקה קפדנית של מטענים של תוצרי גידולים חקלאיים או בעלי חיים לאיתור פטריות המוכרות כמחוללי מחלות בבני אדם, למשל, או הקפדה הדוקה יותר בביקורת המכס בשדות תעופה על נעליים או ציוד מכוסים בבוץ, או איסור הכנסת חומר צמחי על ידי תיירים כפי שנהוג באוסטריה ובניו זילנד – כל אלה יסייעו לא רק במניעת מחלות, אלא גם בהקטנת הסיכון לזיווגים לא רצויים בין פטריות.
צריך להשקיע כסף רב יותר בפיתוח תרופות חדשות ומשופרות נגד פטריות. מכשול גדול כאן הוא הקרבה שלנו אליהן: אנחנו כמעט דודנים ראשונים באילן היוחסין של החיים. הפטריות ובעלי החיים התפצלו במהלך האבולוציה מאוחר יותר מכל קבוצה גדולה אחרת של אורגניזמים. אמנם בשל הקרבה הזאת השמרים הם מודלים מצוינים לחקר הביולוגיה של יונקים, אבל היא מקשה מאוד כשהם מדביקים בני אדם. "העובדה שהן [קרובות אלינו כל כך] היא בעיה אדירה מפני שחלק גדול מן המנגנונים התוך-תאיים שלהן משותפים לנו," אומר הייטמן,"לכן קשה יותר למצוא מטרות ייחודיות לפעולתן של תרופות נגד פטריות." יעילותן של התרופות שיש בידינו בדרך כלל צנועה למדי בהפחתת התמותה ממחלה פטרייתית פולשנית, והן עלולות לגרום לתופעות לוואי רעילות או לתגובות בין-תרופתיות שליליות. מעט חומרים אנטי-פטרייתיים נמצאים כעת בפיתוח. תרכיבי חיסון נוגדי פטריות הם קו הגנה נוסף. אך מעטים מהם הגיעו לשלב של ניסוי קליני, ולפי שעה אין חיסון זמין לבני אדם. פיתוח תרכיבים נגד פטריות עשוי להיות פוליסת ביטוח טובה אם יקרה הרע מכול, והם יוכלו לעזור לרבים המצויים כבר עכשיו בסיכון מוגבר לחלות במחלה פטרייתית.
לסיפור של ק' גאטי נלווית הערת שוליים מבשרת רע. VGIIa ו- VGIIb כבר התפשטו לאורגון, אבל VGIIc הופיע שם לראשונה ב-2005, לפני שהזנים מהאי ונקובר, a ו-b, הופיעו בארה"ב. בדיקות נרחבות של דגימות מן האי ונקובר מראות ש-VGIIc לא היה שם מעולם. אנליזה גנטית של הזן VGIIc מאורגון מראה בבירור שהוא אינו צאצא של זיווג פשוט בין VGIIa ובין VGIIb. התצפיות האלה מרמזות שלא הייתה התפרצות אחת של זן חדש אלים יותר בצפון-מערב היבשת, אלא שתיים.
"זה נראה כמו התפרצות בתוך התפרצות, שעשויים להיות להן מקורות שונים," כתב הייטמן לאחרונה בדוח למכון לרפואה. "זה נראה כמו שני חלוקי אבן שנזרקו לבריכה זה אחרי זה וחוללו מעגלי אדוות קונצנטריים, שמתפשטים עכשיו ומצטלבים אלה באלה." במילים אחרות, ההתפרצות הבו זמנית כמעט של VGIIa ו-b באי ונקובר וזו של VGIIc באורגון אפשר שהייתה שני מאורעות שקרו כמעט יחד בצירוף מקרים מדהים, אם כי שניהם נבעו אולי מאותם תנאי סביבה. התפרצויות כאלה לא היו ידועות לפני 1999, ועכשיו שתיים התרחשו זו אחר זו בתוך שבע שנים בלבד. הגילוי הזה מדגיש את אחת הוודאויות המעטות בסיפור הזה, של אנשים משתעלים, עטלפים מכוסי עובש ועצים מוכי כימשון: המעטה בערכו של הכישרון של פטריות לנדוד לפונדקאים חדשים ולשגשג בהם בעולם המתחמם והמתכווץ שלנו היא הימור רע מאוד.
לקריאה נוספת
- Global Warming Will Bring New Fungal Diseases for Mammals. Monica A. Garcia-Solache and Arturo Casadevall in mBio, Vol. 1, No. 1; April 2010
- Sexual Reproduction, Evolution, and Adaptation of Cryptococcus gattii in the Pacific Northwest Outbreak. Joseph Heitman, Edmond J. Byrnes III and John R. Perfect in Fungal Diseases: An Emerging Threat to Human, Animal, and Plant Health. National Academies Press, 2011
- Hidden Killers: Human Fungal Infections. Gordon D. Brown, David W. Denning, Neil A. R. Gow, Stuart M. Levitz, Mihai G. Netea and Theodore C. White in Science Translational Medicine, Vol. 4, No. 165; December 19, 2012


